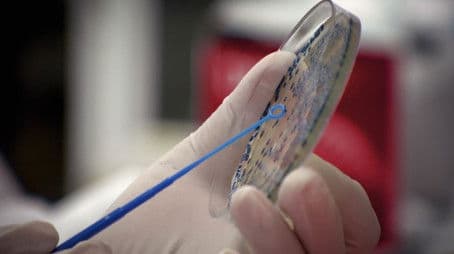
The Superbug Era

Dr Norman Swan uncovers the gripping stories and life-changing scientific breakthroughs from our past clashes with deadly respiratory viruses.



Dr Norman Swan presents the compelling stories of scientists, doctors and public health experts who fight the deadly viruses that cross-over from animals to humans.

Dr Norman Swan speaks with leading doctors and scientists from around the world sounding the alarm about superbugs, a microbial threat that many predict will be worse than the COVID-19 pandemic.
Made with Love By Anonymous
This project uses the TMDB API but is not endorsed or certified by TMDB.